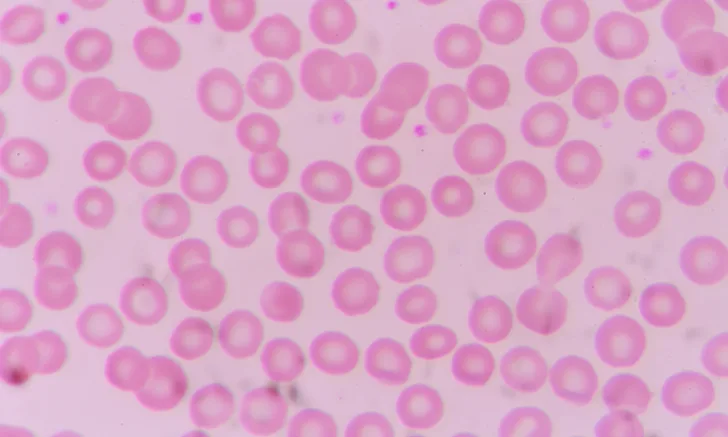

Differential Diagnosis: Thrombocytosis
Julie Allen, BVMS, MS, MRCVS, DACVIM (SAIM), DACVP (Clinical), Durham, North Carolina
Following are differential diagnoses for patients presented with thrombocytosis.
Drug-induced response (eg, to vincristine, epinephrine, possibly a glucocorticoid)
Iron deficiency
Physiologic reaction
To epinephrine (eg, due to trauma, exercise, or excitement)
Postsplenectomy
Primary thrombocytosis
Acute megakaryocytic leukemia
Chronic myeloproliferative disease
Chronic basophilic leukemia
Chronic myeloid leukemia
Essential thrombocythemia
Other myelodysplastic/ myeloproliferative neoplasm
Polycythemia vera
Primary myelofibrosis
Pseudothrombocytosis
RBC ghosts or fragments, fragile leukocytes, microorganisms, or lipemia
Reactive thrombocytosis
Hematopoietic/nonhematopoietic neoplasia
Hyperadrenocorticism
Infection
Inflammation (eg, immune-mediated or hepatobiliary disease)
Postsplenectomy
Rebound from thrombocytopenia
Trauma